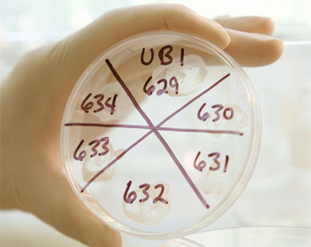
Laboratory Equipment & Chemicals

Laboratory Equipment & Chemicals
We have a dedicated team that specialises in sourcing packages of high quality equipment that meets technical expectation from different manufacturers, and consolidating all items into one single cost effective shipment.
We have a dedicated team that specialises in sourcing packages of high quality equipment that meets technical expectation from different manufacturers, and consolidating all items into one single cost effective shipment.
Our customers include universities, government as well as privately funded environmental, medical and
industrial laboratories all over the world.
Our highly experienced and skilled staff will carefully interpret your specifications and requirements and offer
the best equipment at affordable price delivered directly to your laboratory.
We also supply a wide range of packed as well as bulk chemicals, reagents and solvents for laboratory and pharmaceutical applications in general, analytical, HPLC and pharmaceutical grades.
From a single piece of equipment or laboratory apparatus to a fully equipped laboratory inclusive of installation, commissioning and training – whatever you are looking for, our team will take an excellent care of all your needs providing you with a dedicated and reliable service tailored around your particular requirements.
